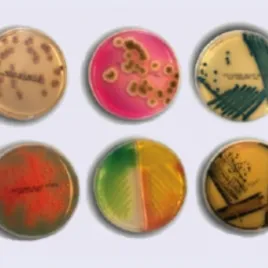

Трипказо-соевый агар (TSA) с 4 нейтрализаторами (двойной пакет)(30мл)
Информация
TSA w/4 NEUTRALISANT (DOUBLE BAG) (30ml)- Трипказо-соевый агар (TSA) с 4 нейтрализаторами (двойной пакет)(30мл)
Универсальная питательная среда для выделения и культивирования микроорганизмов с нейтрализаторами.
Категория:
Microorganism: Aspergillus brasiliensis, Bacillus subtilis, Candida albicans, Eschrichia coli, Pseudomonas aeruginosa, Staphylococcus aureus, Staphylococcus epidermidis
Производитель:
Микроорганизм | Инокулят (КОЕ) | Результаты |
Рост | ||
Staphylococcus aureus ATCC 6538 | 10-100 | Хороший |
Escherichia coli ATCC 8739 | 10-100 | Хороший |
Pseudomonas aeroginosa ATCC 9027 | 10-100 | Хороший |
Candida albicans ATCC 10231 | 10-100 | Хороший |
Aspergillus brasiliensis ATCC 16404 | 10-100 | Хороший |
Bacillus subtilis ATCC 6633 | 10-100 | Хороший |
Staphylococcus epidermidis ATCC 12228 | 10-100 | Хороший |
В триптическом соевом агаре комбинация казеина и соевых пептонов делает среду питательной, обеспечивая органический азот, в частности аминокислоты и пептиды с более длинными цепями. Хлорид натрия поддерживает осмотическое равновесие. Агар является загустителем. Нейтрализующие добавки: полисорбат (Твин) 80, глицин, тиосульфат натрия, гистидин, лецитин и тиогликолят натрия, нивелируют ингибирующее действие большинства дезинфицирующих и антисептических средств. Нейтрализующая эффективность гистидина была продемонстрирована против формальдегида и веществ, выделяющих формальдегид. Тиосульфат натрия инактивирует гипохлорит натрия и подкисленный хлорит натрия. Лецитин, особенно в сочетании с полисорбатом 80, эффективен против четвертичных аммониевых соединений, амфотерных поверхностно-активных веществ, бензамидинов, хлоргексидинов и деквадина. Полисорбат 80 инактивирует бензиловый спирт, карбанилиды, дихлорбензиловые спирты, бензойную кислоту, п-гидроксибензойную кислоту и ее эфиры, фенолы, фенилэтиловые спирты и золбролы.
Tемпература хранения 2-12°С
Срок хранения 5 месяцев
Tемпература хранения c гамма облучением 2-25°С
Срок хранения c гамма облучением 4 месяца
Добавление нейтрализующих агентов TLHTh (Твин 80 - лецитин - гистидин - тиосульфат натрия)
Микробиологический контроль: Инкубация 24-48 часов при температуре 35±2 ºC и 25±2 ºC 5 дней
Упаковка содержит 10 штук контактных чашек